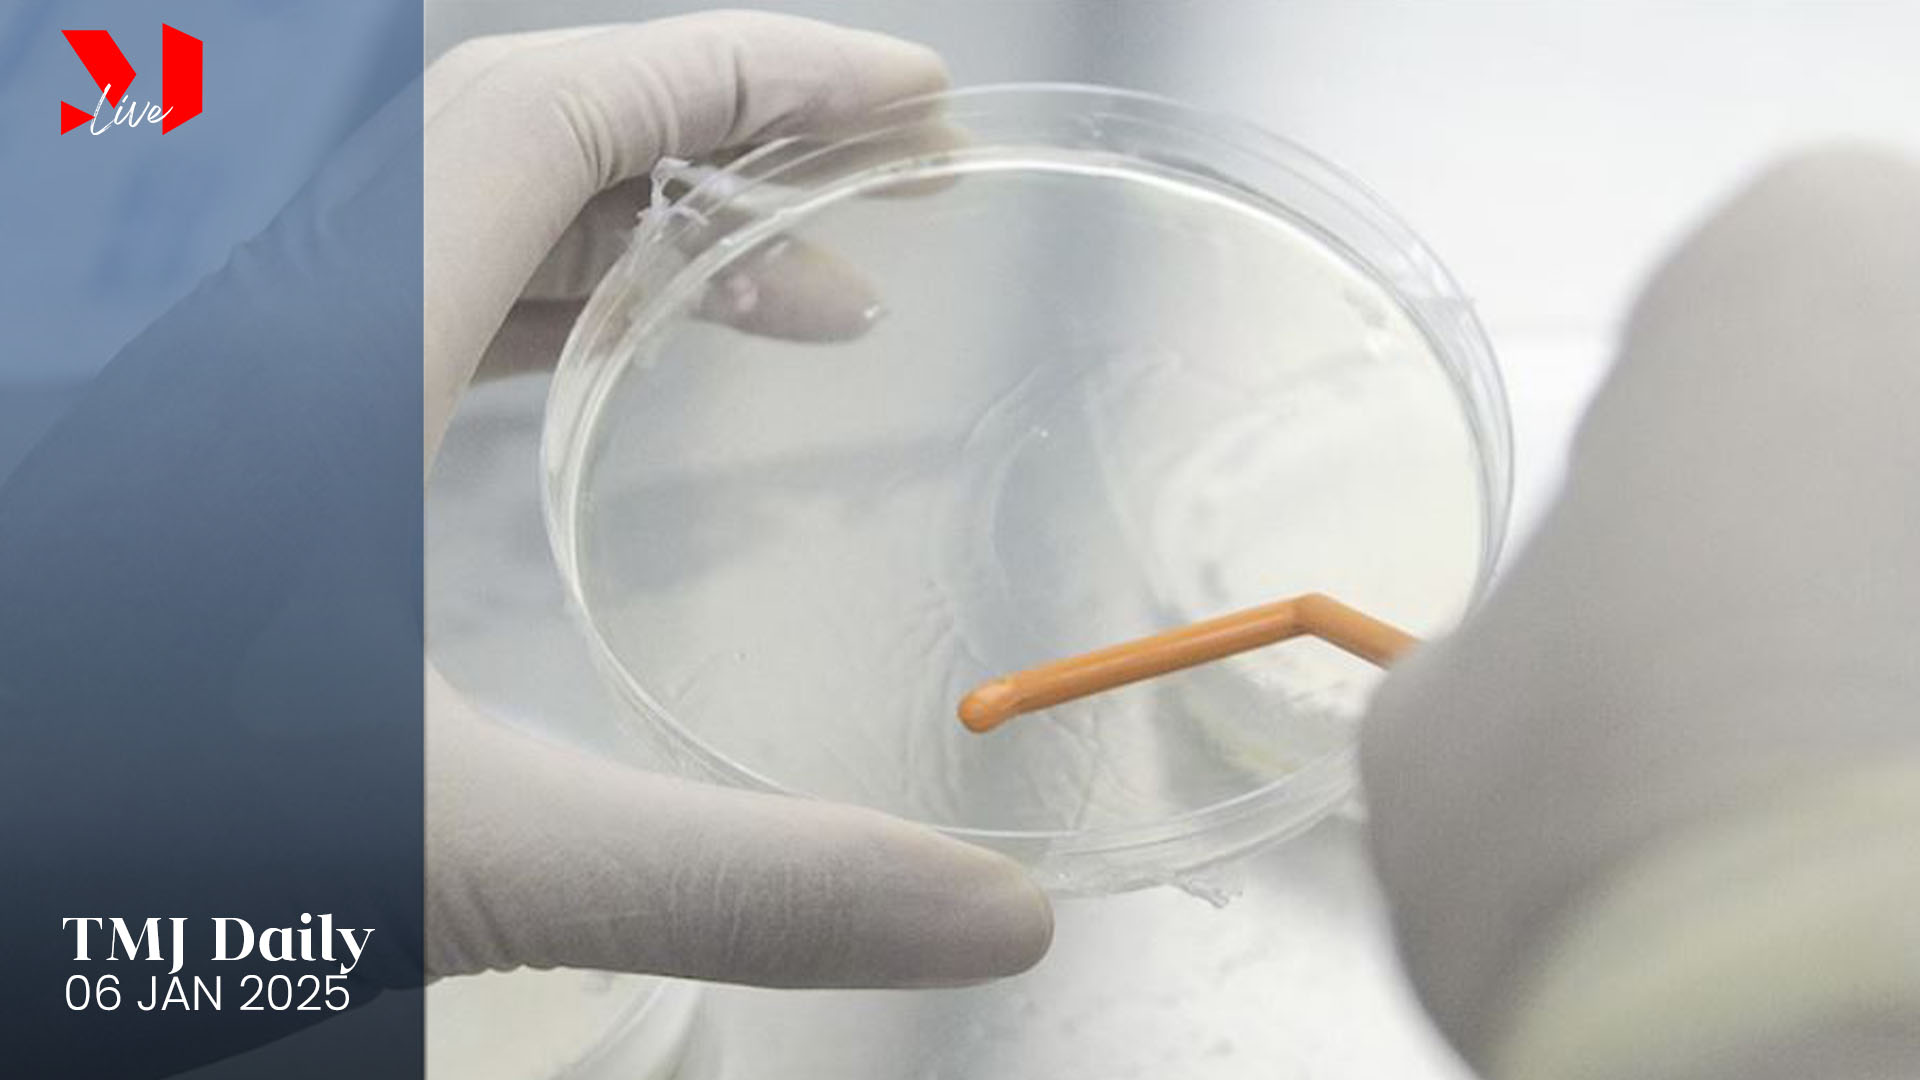
post-thumbnail

എച്ച്എംപിവി: ആദ്യ കേസ് ബംഗളുരുവില്
ഇന്ത്യയില് ആദ്യ എച്ച്എംപിവി ആദ്യ കേസ് ബംഗളുരുവില് റിപ്പോര്ട്ട് ചെയ്തു. എട്ടുമാസം പ്രായമുള്ള കുഞ്ഞിനാണ് രോഗബാധ കണ്ടെത്തിയത്. ജനുവരി 2ന് കുഞ്ഞില് നിന്നും ശേഖരിച്ച സാമ്പിള് ആണ് പോസിറ്റീവായത്.
കുഞ്ഞും കുടുംബവും സമീപകാലത്ത് യാത്ര ചെയ്തിട്ടില്ല. ആശങ്കാജനകമായ ലക്ഷണങ്ങള് ഇല്ലെന്നും ബ്രഹത് ബംഗളുരു മഹാനഗര പാലികെയുടെ ആരോഗ്യ വകുപ്പ് അധികൃതര് പറഞ്ഞു.
സംസ്ഥാന സര്ക്കാരിന്റെ ആരോഗ്യ വകുപ്പ് കുഞ്ഞിന്റെ സാമ്പിള് പരിശോധിച്ച് രോഗം സ്ഥിരീകരിച്ചിട്ടില്ല. എങ്കിലും സ്വകാര്യ ആശുപത്രിയുടെ കണ്ടെത്തല് ശരിയാണെന്ന് അംഗീകരിച്ചു. അവരുടെ പരിശോധന പ്രക്രിയയുടെ കൃത്യതയെ ഞങ്ങള് വിശ്വസിക്കുന്നുവെന്ന് ആരോഗ്യ വകുപ്പ് ഉദ്യോഗസ്ഥര് പറഞ്ഞു.
സാധാരണ എച്ച്എംപിവി കുട്ടികളെയാണ് ബാധിക്കുന്നത്. നിലവില് ആഗോളതലത്തിലെ പനി രോഗികളില് 0.7 ശതമാനവും എച്ച്എംപിവി രോഗബാധയാണ്. എന്നാല്, കുഞ്ഞിനെ ബാധിച്ച വൈറസിന്റെ കൃത്യമായ ഇനത്തിന്റെ വിവരം ലഭ്യമല്ലെന്ന് സര്ക്കാര് ആരോഗ്യ അധികൃതര് പറയുന്നു.


